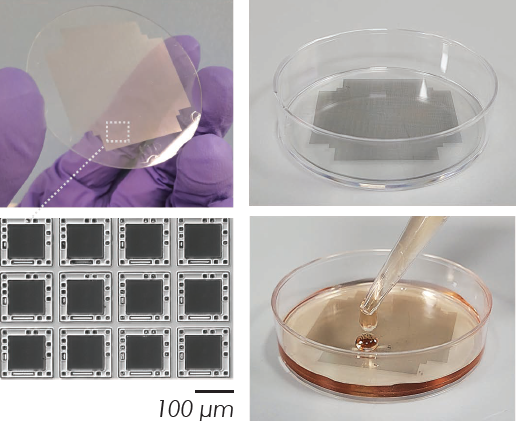
Accelerating cell assays with frozen transfected cells

This article is based on a poster originally authored by Blaise Louis, Serena Belluschi, Daniel Weekes, Tom Mitchell, Holly Herbert, Tarun Vemulkar and Jeroen Verheyen, which was presented at ELRIG Drug Discovery 2024 in affiliation with Semarion Ltd.
This poster is being hosted on this website in its raw form, without modifications. It has not undergone peer review but has been reviewed to meet AZoNetwork's editorial quality standards. The information contained is for informational purposes only and should not be considered validated by independent peer assessment.

Adherent cell assays are crucial for drug discovery but often suffer from long preparation times, limiting workflow efficiency. SemaCyte® microcarriers allow the cryopreservation of large batches of assay-ready cells, which can be used just one hour after thawing.
In this study, the researchers show that A549 cells transfected with a p53:MDM2 NanoBRET pair can be frozen in bulk and recovered without losing viability or transfection efficiency.
NanoBRET ratios remained consistent two hours and 24 hours post-thaw, with Nutlin-3 used to measure interference with the protein-protein interaction. Here, the SemaCyte® technology accelerated assays eight-fold and enabled more flexible screening campaigns by eliminating the 2-3 day cell preparation step.
Freeze-adhered cells inside cryovials using SemaCyte® microcarriers
Image Credit: Blaise Louis et al., in partnership with Semarion Ltd.
SemaCytes are flat microcarriers with a 100 μm2 growth area and cell-repellent walls. They function as ultra-miniaturized wells suspended in a liquid that can be moved with manual and robotic liquid handling tools and can be spatially oriented due to their magnetic properties.
In conventional methods, cells are often cultured continuously over several weeks to ensure enough material for assays. In contrast, SemaCytes loaded with cells can be cryopreserved and thawed when needed, retaining their local confluency and adherent characteristics.

Standard cell assay workflow. Image Credit: Semarion

SemaCyte® cell assay workflow. Image Credit: Blaise Louis et al., in partnership with Semarion Ltd.

Arrayed SD20. Image Credit: Blaise Louis et al., in partnership with Semarion Ltd.

Dispensed SemaCytes. Image Credit: Blaise Louis et al., in partnership with Semarion Ltd.
The SemaCyte® Seeding Dish (SD20) has 50,000 arrayed microcarriers onto which cells can be seeded. When the desired confluency and morphology are achieved, the microcarriers are dislodged from the array and collected.
SemaCytes from a single SD20 provide 2-10 microplates worth of experiments for high-throughput screening, high-content imaging, or other cell assays. Alternatively, SemaCytes can be aliquoted and batch frozen for future use.
Key advantages of SemaCyte® microcarriers
Enhanced flexibility
- Move and freeze adherent cells without losing their natural morphology
- Cells on SemaCytes can be dispensed and assayed within one hour of thawing
- Batch production of assay-ready cells ensures uniformity across longitudinal studies
Increased throughput
- Reduces the time spent on cell preparation and maintenance
- Ultra-miniaturizing assays within microwells result in a reduction in costs and plasticware usage
Resource efficiency
- Reduces the cells per well without compromising local confluency
- More data generated per cell sample
Assay-ready A549 and human neural stem cells


(A) A549 cells maintain their adherent, spread morphology at one hour post-thawing. (B) High levels of cell viability are seen across multiple vials from the same batch with recovery rates typically over 85 % (C). (D, E) Thawed A549 cells on SemaCytes also show high levels of mitochondrial integrity at one hour post-thaw. (F) Production of assay-ready adherent human neural stem cells. (G, H) These cells show expected expression of the Ki67 proliferation marker as early as four hours post-thaw and maintain proliferation capacity up to 7 days post-thaw. (I) Human neural stem cells also maintain the expression of the key markers (J) SOX2 and (K) Nestin throughout this process. Image Credit: Blaise Louis et al., in partnership with Semarion Ltd.
Assay-ready NanoBRET transfected A549 cells


(A) A549 cells were seeded onto an SD20, transfected using Lipofectamine 3000, released, aliquoted, and then frozen. (B) GFP transfection had an efficiency of 30-40% before and after freezing. (C) A549 cells were transfected with a p53:MDM2 NanoBRET Protein-Protein Interaction pair and frozen for later use. Transfected cells displayed high levels of cell viability post-thaw. (D) 50 SemaCytes per well were dispensed into 384-well plates, and NanoBRET ratios were measured with the BMG FLUOstar Omega. Ratios were consistent and stable 2 and 24 hours after thawing. (E) Nutlin-3 was added 1 hour after thawing and incubated for 4 hours to measure its interference with the p53:MDM2 interaction. (F) Well plate controls and SemaCytes were transfected in parallel and showed comparable BRET ratios. Image Credit: Blaise Louis et al., in partnership with Semarion Ltd.
About Semarion
Semarion is a spin-out company from the Cavendish Laboratory at the University of Cambridge, operating at the edge of the physical and life sciences. By using microchip industry materials and techniques we are revolutionizing in vitro research on cell models to help create better medicines, faster.
Our SemaCyte® cell assaying microcarriers are flat and function as ultra-miniaturized, steerable wells to which small colonies of adherent cells are attached. We can now move and control adherent cells in liquid to accelerate, miniaturize, and multiplex cell assays. This unique approach drives 10x gains in drug screening applications such as molecular profiling, cell panel screening, or patient-derived cell work.
About ELRIG (UK) Ltd.
The European Laboratory Research & Innovation Group (ELRIG) is a leading European not-for-profit organization that exists to provide outstanding scientific content to the life science community. The foundation of the organization is based on the use and application of automation, robotics and instrumentation in life science laboratories, but over time, we have evolved to respond to the needs of biopharma by developing scientific programmes that focus on cutting-edge research areas that have the potential to revolutionize drug discovery.
Comprised of a global community of over 12,000 life science professionals, participating in our events, whether it be at one of our scientific conferences or one of our networking meetings, will enable any of our community to exchange information, within disciplines and across academic and biopharmaceutical organizations, on an open access basis, as all our events are free-of-charge to attend!
Our values
Our values are to always ensure the highest quality of content and that content will be made readily accessible to all, and that we will always be an inclusive organization, serving a diverse scientific network. In addition, ELRIG will always be a volunteer led organization, run by and for the life sciences community, on a not-for-profit basis.
Our purpose
ELRIG is a company whose purpose is to bring the life science and drug discovery communities together to learn, share, connect, innovate and collaborate, on an open access basis. We achieve this through the provision of world class conferences, networking events, webinars and digital content.
Sponsored Content Policy: News-Medical.net publishes articles and related content that may be derived from sources where we have existing commercial relationships, provided such content adds value to the core editorial ethos of News-Medical.Net which is to educate and inform site visitors interested in medical research, science, medical devices and treatments.
Last Updated: Nov 13, 2025